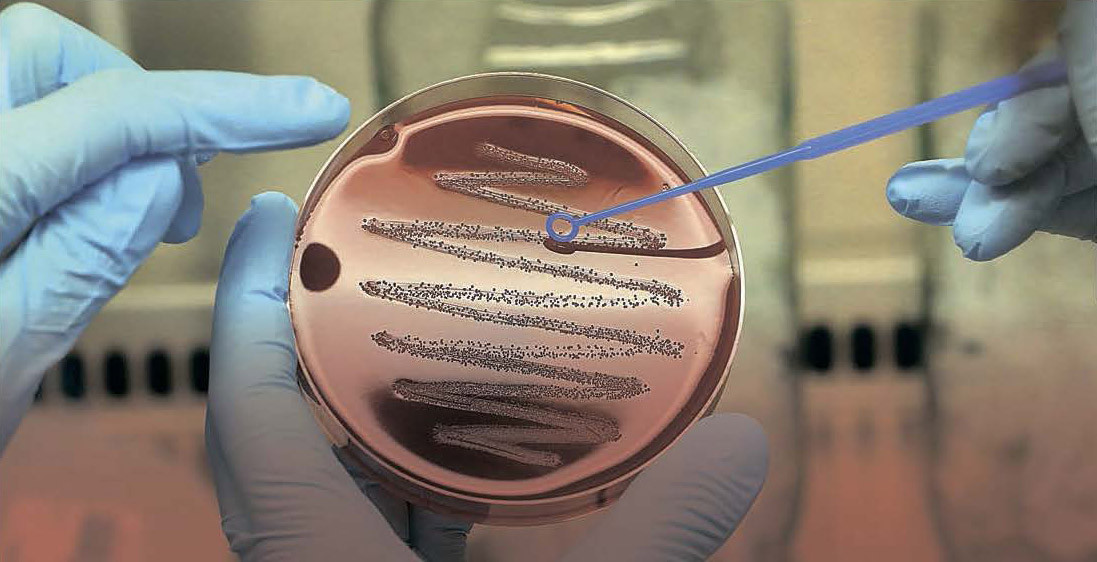

Новые штаммы ускорят экономику
Российским ученым могут разрешить работать с генно-модифицированными микроорганизмами. Это ускорит вывод на рынок необходимых экономике ферментов, кормовых и пищевых добавок, повышающих эффективность производства
Как стало известно «Моноклю», комитет Совета федерации по науке и образованию в ближайшее время направит в Госдуму проект поправок к закону о генно-инженерной деятельности, призванный ослабить ограничения, наложенные на работу с генно-модифицированными организмами (ГМО). Как известно, в России в отличие от большинства стран мира действует запрет на использование ГМО во всех сферах, кроме медицины («Спутник V» — в чистом виде генная модификация). Это связывает руки ученым: они не могут создавать микроорганизмы с новыми свойствами, необходимыми для более продуктивной выработки различных ферментов. Такие ферменты широко применяются во многих отраслях экономики — начиная с сельского хозяйства, пищевой, текстильной и химической промышленности до нефтехимии и горнорудного дела, — поскольку повышают качество продуктов и ускоряют процесс их производства.
Сегодня Россия на 90% зависит от импорта ферментов, хотя уже имеет мощности для покрытия половины потребностей рынка. Законодательное послабление позволит легально использовать полученные путем генной инженерии микроорганизмы для производства чистых и безопасных ферментов.
Бактерии крутят планету
Микроорганизмы (бактерии, вирусы, дрожжи, грибы и простейшие водоросли) — основа современных биотехнологий. Они подлинные властелины мира: например, благодаря цианобактериям на Земле появилась атмосфера, содержащая кислород. Они участвуют почти во всех реакциях биохимического синтеза снаружи и внутри нас; наконец, они делают мировую экономику более эффективной. И все благодаря уникальному свойству — способности производить в процессе жизнедеятельности разного рода ферменты. Ферменты, в свою очередь, являются катализатором, ускорителем разных реакций, позволяющих получать вещества с новыми свойствами, а то и вовсе новые вещества. При этом ученые описали и изучили всего 5% от известных видов микроорганизмов, что открывает головокружительные перспективы для человеческой цивилизации, в том числе для освоения космоса.
Сейчас в промышленности применяются такие белки или элементы, как альфа- и бета-амилаза, глюкоамилаза, целлюлаза, протеаза, липаза и еще 50–60 видов ферментов. Например, аминокислоты, полученные с помощью бактерий, повышают конверсию производства мяса: животные быстрее набирают вес, что снижает себестоимость. При переработке мяса ферменты улучшают вкус, эластичность волокон, цвет, сохранность и прочее. Микроорганизмы для ферментации используют при производстве кислот, спиртов, пива, кисломолочной продукции, в крахмалопаточной промышленности, хлебопечении и кондитерском деле, виноделии и других отраслях. В медицине продукты жизнедеятельности бактерий представлены про- и пребиотиками, их добавляют в генные и биопрепараты. Ферменты также играют важную роль в переработке сельхозсырья, производстве моющих средств (жирорастворители), обработке текстиля, в лакокрасочной и бумажной промышленности и т. д. Наконец, бактерии помогают увеличить нефтедобычу и повысить качество топлива, облегчают извлечение редкоземельных металлов (их кислоты разъедают породу, скрывающую микрочастицы ценных элементов). Из мирового оборота ферментов, который оценивается в 2 млрд долларов в год, около 0,9 млрд применяется при производстве биотоплива, остальное приходится в основном на промышленные товары и пищевую отрасль. «Россия ежегодно импортирует 13–14 тысяч тонн ферментов, в основном для кормовых добавок и пищевого производства, — поясняет заведующий лабораторией биотехнологии ферментов ФИЦ “Фундаментальные основы биотехнологии” РАН Аркадий Синицын. — Импорт у нас составляет до 90 процентов рынка. При этом в стране имеются собственные мощности для производства, наши предприятия могут покрыть до 30–40 процентов потребности внутреннего рынка. Есть и возможности наращивать объемы».